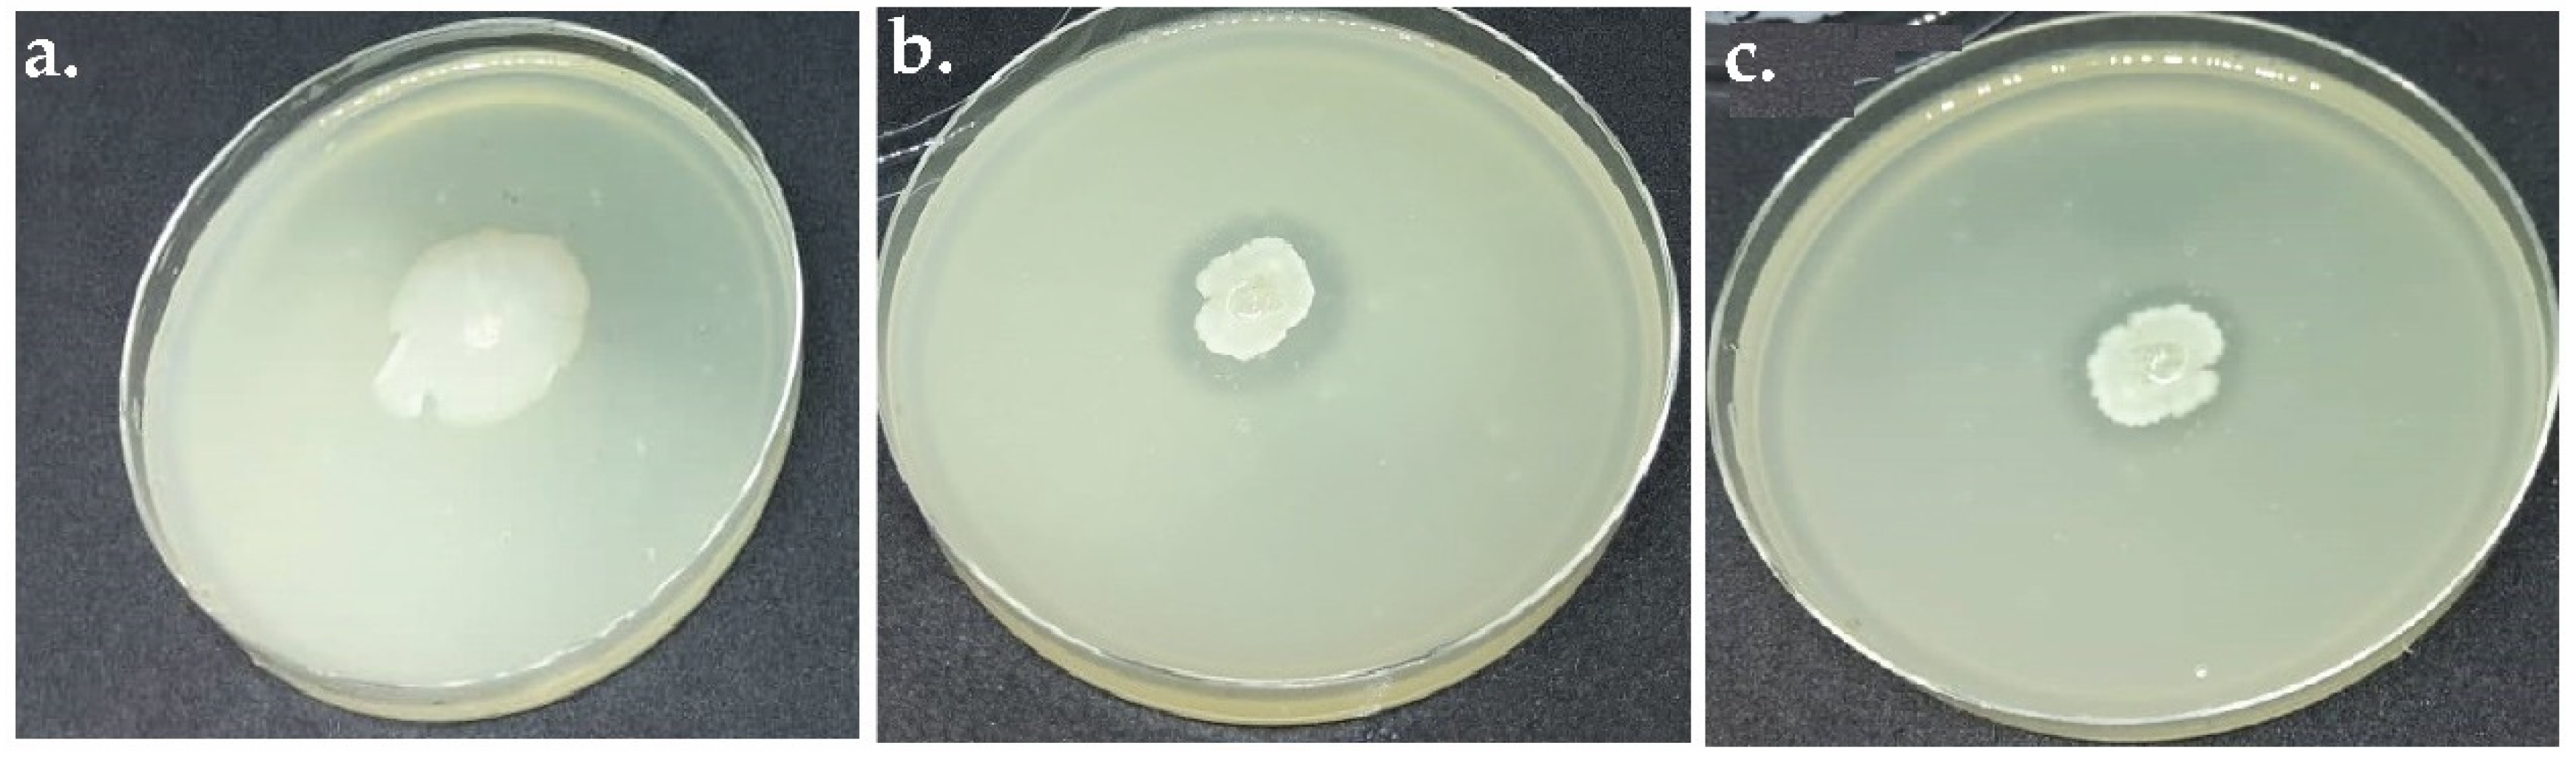
Applsci 12 07136 g001 Applsci 12 07136 g001

Augmented Retting Effect on Kenaf Fibers Using Alkalophilic Pectinase-Producing Bacteria in Combination with Water Solvents
Abstract
1. Introduction
2. Materials and Methods
2.1. Obtaining Alkalophilic Pectinase-Producing Bacteria
2.2. Experimental Procedure
2.3. Determination of the Enzyme Activity
2.4. Fried Score Test
2.5. Physical Fibers’ Quality
2.6. Fiber Composition Analysis
2.7. FTIR Spectra Analysis
3. Results and Discussion
3.1. Alakalophilic Pectinase-Producing Bacteria
3.2. Augmented Kenaf Retting Using APPB Combined with Water Solvents
3.3. Pectinase Enzyme Activity
3.4. Degree of Retting
3.5. Fiber Composition Analysis
3.6. Physical Fiber Quality
3.6.1. Surface Morphology
3.6.2. Fiber Diameter and Fineness
3.7. FTIR Spectra
4. Conclusions
Author Contributions
Funding
Institutional Review Board Statement
Informed Consent Statement
Data Availability Statement
Acknowledgments
Conflicts of Interest
References
- Papadopoulou, E.; Bikiaris, D.; Chrysafis, K.; Wladyka-Przybylak, M.; Wesolek, D.; Mankowski, J.; Kolodziej, J.; Baraniecki, P.; Bujnowicz, K.; Gronberg, V. Value-added industrial products from bast fiber crops. Ind. Crops Prod. 2015, 68, 116–125. [Google Scholar] [CrossRef]
- Tezara, C.; Siregar, J.P.; Lim, H.; Fauzi, F.; Yazdi, M.H.; Moey, L.; Lim, J. Factors that affect the mechanical properties of kenaf fiber reinforced polymer: A review. J. Mech. Eng. Sci. 2016, 10, 2159–2175. [Google Scholar]
- Narkpiban, K.; Poonsawat, T. Optimizing Cellulose Extraction from Kenaf (Hibiscus Cannabinus L.) Fiber by Selective Retting and Hydrothermal Pretreatment. J. Nat. Fibers 2020, 19, 700–713. [Google Scholar] [CrossRef]
- Zimniewska, M.; Wladyka-Przybylak, M.; Mankowski, J. Cellulosic bast fibers, their structure and properties suitable for composite applications. In Cellulose Fibers: Bio-and Nano-Polymer Composites; Springer: Berlin/Heidelberg, Germany, 2011; pp. 97–119. [Google Scholar]
- Ali, M.E.; Yong, C.K.; Ching, Y.C.; Chuah, C.H.; Liou, N.-S. Effect of single and double stage chemically treated kenaf fibers on mechanical properties of polyvinyl alcohol film. BioResources 2015, 10, 822–838. [Google Scholar] [CrossRef]
- Mondal, D.K.; Kaviraj, A. Ecotoxicological effects of jute retting on the survival of two freshwater fish and two invertebrates. Ecotoxicology 2008, 17, 207–211. [Google Scholar] [CrossRef]
- Nabiha Huda, A.; Tajaddin, R.M.; Ahmad, Z.; Nazrin, O.M. Determination of optimum debark time in retting process of kenaf fiber production. Int. Sustain. Civ. Eng. J. 2012, 1, 14–18. [Google Scholar]
- Ray, D.P.; Saha, S.C.; Sarkar, A.; Ghosh, R.K. Production of quality jute fibre through accelerated retting. Int. J. Bioresour. Sci. 2016, 3, 57. [Google Scholar] [CrossRef][Green Version]
- Majumdar, B.; Chattopadhyay, L.; Barai, S.; Saha, A.; Sarkar, S.; Sarkar, S.; Mazumdar, S.; Saha, R.; Jha, S. Impact of conventional retting of jute (Corchorus spp.) on the environmental quality of water: A case study. Environ. Monit. Assess. 2019, 191, 440. [Google Scholar] [CrossRef]
- Zawani, Z.; Abdullah, L.C.; Abdan, K. Characterization of kenaf fibre-retting wastewater. Int. J. Sci. Res. 2015, 4, 314–317. [Google Scholar]
- Van Dam, J.E.; Bos, H.L. The environmental impact of fibre crops in industrial applications. In Hintergrundpapier zu: Van Dam, JEG; FAO: Rome, Italy, 2004. [Google Scholar]
- Hossain, M.M.; Siddiquee, S.; Kumar, V. Water Sources Derived Bio Retting Effect on Kenaf Fiber Compositions. J. Nat. Fibers 2021, 18, 1–14. [Google Scholar] [CrossRef]
- Zhang, L.; Zhu, R.; Chen, J.; Chen, J.; Feng, X. Seawater-retting treatment of hemp and characterization of bacterial strains involved in the retting process. Process Biochem. 2008, 43, 1195–1201. [Google Scholar] [CrossRef]
- Fernando, D.; Thygesen, A.; Meyer, A.S.; Daniel, G. Elucidating field retting mechanisms of hemp fibres for biocomposites: Effects of microbial actions and interactions on the cellular micro-morphology and ultrastructure of hemp stems and bast fibres. BioResources 2019, 14, 4047–4084. [Google Scholar] [CrossRef]
- Foulk, J.; Akin, D.; Dodd, R. Influence of pectinolytic enzymes on retting effectiveness and resultant fiber properties. BioResources 2008, 3, 155–169. [Google Scholar]
- Komuraiah, A.; Kumar, N.S.; Prasad, B.D. Chemical composition of natural fibers and its influence on their mechanical properties. Mech. Compos. Mater. 2014, 50, 359–376. [Google Scholar] [CrossRef]
- Sisti, L.; Totaro, G.; Vannini, M.; Celli, A. Retting process as a pretreatment of natural fibers for the development of polymer composites. In Lignocellulosic Composite Materials; Springer: Berlin/Heidelberg, Germany, 2018; pp. 97–135. [Google Scholar]
- Mao, K.; Chen, H.; Qi, H.; Qiu, Z.; Zhang, L.; Zhou, J. Visual degumming process of ramie fiber using a microbial consortium RAMCD407. Cellulose 2019, 26, 3513–3528. [Google Scholar] [CrossRef]
- Duan, S.W.; Cheng, L.F.; Feng, X.Y.; Yang, Q.; Liu, Z.Y.; Zheng, K.; Peng, Y.D. Insights on bio-degumming of kenaf bast based on metagenomic and proteomics. BMC Genom. 2020, 21, 121. [Google Scholar] [CrossRef]
- Visi, D.K.; D’Souza, N.; Ayre, B.G.; Webber, C.L., III; Allen, M.S. Investigation of the bacterial retting community of kenaf (Hibiscus cannabinus) under different conditions using next-generation semiconductor sequencing. J. Ind. Microbiol. Biotechnol. 2013, 40, 465–475. [Google Scholar] [CrossRef]
- Zhao, D.; Liu, P.; Pan, C.; Du, R.; Ping, W.; Ge, J. Bacterial succession and metabolite changes during flax (Linum usitatissimum L.) retting with Bacillus cereus HDYM-02. Sci. Rep. 2016, 6, 31812. [Google Scholar] [CrossRef]
- Allison, S.D. Cheaters, diffusion and nutrients constrain decomposition by microbial enzymes in spatially structured environments. Ecol. Lett. 2005, 8, 626–635. [Google Scholar] [CrossRef]
- Ge, J.; Yang, Z.; Du, R.; Zhang, L.; Ping, W.; Zhao, D. Production of Pectinolytic Enzymes by Two Bacillus spp. Strains and Their Application in Flax Degumming. Trans. Tianjin Univ. 2019, 25, 413–419. [Google Scholar] [CrossRef]
- Ghazala, I.; Sayari, N.; Romdhane, M.B.; Ellouz-Chaabouni, S.; Haddar, A. Assessment of pectinase production by Bacillus mojavensis I4 using an economical substrate and its potential application in oil sesame extraction. J. Food Sci. Technol. 2015, 52, 7710–7722. [Google Scholar] [CrossRef] [PubMed][Green Version]
- Hasan, R.; Aktar, N.; Kabir, S.M.T.; Honi, U.; Halim, A.; Islam, R.; Sarker, M.D.H.; Haque, M.S.; Alam, M.M.; Islam, M.S. Pectinolytic Bacterial Consortia Reduce Jute Retting Period and Improve Fibre Quality. Sci. Rep. 2020, 10, 5174. [Google Scholar] [CrossRef] [PubMed]
- Das, S.; Majumdar, B.; Saha, A.R. Biodegradation of Plant Pectin and Hemicelluloses with Three Novel Bacillus pumilus Strains and Their Combined Application for Quality Jute Fibre Production. Agric. Res. 2015, 4, 354–364. [Google Scholar] [CrossRef]
- Kohli, P.; Gupta, R. Alkaline pectinases: A review. Biocatal. Agric. Biotechnol. 2015, 4, 279–285. [Google Scholar] [CrossRef]
- Guadie, A.; Tizazu, S.; Melese, M.; Guo, W.; Ngo, H.H.; Xia, S. Biodecolorization of textile azo dye using Bacillus sp. strain CH12 isolated from alkaline lake. Biotechnol. Rep. 2017, 15, 92–100. [Google Scholar] [CrossRef]
- Zheng, L.; Du, Y.; Zhang, J. Degumming of ramie fibers by alkalophilic bacteria and their polysaccharide-degrading enzymes. Bioresour. Technol. 2001, 78, 89–94. [Google Scholar] [CrossRef]
- Vos, P.; Garrity, G.; Jones, D.; Krieg, N.R.; Ludwig, W.; Rainey, F.A.; Schleifer, K.-H.; Whitman, W.B. Bergey’s Manual of Systematic Bacteriology: Volume 3: The Firmicutes; Springer Science & Business Media: Berlin/Heidelberg, Germany, 2011; Volume 3. [Google Scholar]
- Cao, J.; Zheng, L.; Chen, S. Screening of pectinase producer from alkalophilic bacteria and study on its potential application in degumming of ramie. Enzym. Microb. Technol. 1992, 14, 1013–1016. [Google Scholar] [CrossRef]
- Miller, G.L. Use of dinitrosalicylic acid reagent for determination of reducing sugar. Anal. Chem. 1959, 31, 426–428. [Google Scholar] [CrossRef]
- Silva, D.; Tokuioshi, K.; da Silva Martins, E.; Da Silva, R.; Gomes, E. Production of pectinase by solid-state fermentation with Penicillium viridicatum RFC3. Process Biochem. 2005, 40, 2885–2889. [Google Scholar] [CrossRef]
- Zhang, J. Biochemical Study and Technical Applications of Fungal Pectinase; Acta Universitatis Upsaliensis: Stockholm, Sweden, 2006. [Google Scholar]
- Munder, F.; Furll, C. Effective processing of bast fiber plants and mechanical properties of the fibers. In Proceedings of the 2004 ASAE Annual Meeting, Ottawa, ON, Canada, 1–4 August 2004; p. 1. [Google Scholar]
- Chen, Y.; Belsham, T.; Laguë, C.; Landry, H.; Peng, Q.; Zhong, W. Fineness and tensile properties of hemp (Cannabis sativa L.) fibres. Biosyst. Eng. 2011, 108, 9–17. [Google Scholar] [CrossRef]
- Madhu, P.; Sanjay, M.; Senthamaraikannan, P.; Pradeep, S.; Saravanakumar, S.; Yogesha, B. A review on synthesis and characterization of commercially available natural fibers: Part-I. J. Nat. Fibers 2018, 16, 1132–1144. [Google Scholar] [CrossRef]
- Punyamurthy, R.; Sampathkumar, D.; Srinivasa, C.V.; Bennehalli, B. Effect of alkali treatment on water absorption of single cellulosic abaca fiber. BioResources 2012, 7, 3515–3524. [Google Scholar]
- George, M.; Mussone, P.G.; Bressler, D.C. Surface and thermal characterization of natural fibres treated with enzymes. Ind. Crops Prod. 2014, 53, 365–373. [Google Scholar] [CrossRef]
- Van Nimmen, E.; De Clerck, K.; Verschuren, J.; Gellynck, K.; Gheysens, T.; Mertens, J.; Van Langenhove, L. FT-IR spectroscopy of spider and silkworm silks: Part I. Different sampling techniques. Vib. Spectrosc. 2008, 46, 63–68. [Google Scholar] [CrossRef]
- Takami, H.; Horikoshi, K. Analysis of the genome of an alkaliphilic Bacillus strain from an industrial point of view. Extremophiles 2000, 4, 99–108. [Google Scholar] [CrossRef]
- Preiss, L.; Hicks, D.B.; Suzuki, S.; Meier, T.; Krulwich, T.A. Alkaliphilic bacteria with impact on industrial applications, concepts of early life forms, and bioenergetics of ATP synthesis. Front. Bioeng. Biotechnol. 2015, 3, 75. [Google Scholar] [CrossRef]
- Datta, S.; Saha, D.; Chattopadhyay, L.; Majumdar, B. Genome comparison identifies different bacillus species in a bast fibre-retting bacterial consortium and provides insights into pectin degrading genes. Sci. Rep. 2020, 10, 8169. [Google Scholar] [CrossRef]
- Cheng, L.; Duan, S.; Feng, X.; Zheng, K.; Yang, Q.; Xu, H.; Luo, W.; Peng, Y. Screening and identification of pectinolytic bacteria for ramie degumming. Text. Res. J. 2021, 91, 1056–1064. [Google Scholar] [CrossRef]
- Brühlmann, F.; Kim, K.S.; Zimmerman, W.; Fiechter, A. Pectinolytic enzymes from actinomycetes for the degumming of ramie bast fibers. Appl. Environ. Microbiol. 1994, 60, 2107–2112. [Google Scholar] [CrossRef]
- Attri, S.; Garg, G. Isolation of microorganisms simultaneously producing xylanase, pectinase and cellulase enzymes using cost effective substrates. J. Innov. Biol. 2014, 1, 45–50. [Google Scholar]
- Mukhopadhya, I.; Moraïs, S.; Laverde-Gomez, J.; Sheridan, P.O.; Walker, A.W.; Kelly, W.; Klieve, A.V.; Ouwerkerk, D.; Duncan, S.H.; Louis, P. Sporulation capability and amylosome conservation among diverse human colonic and rumen isolates of the keystone starch-degrader Ruminococcus bromii. Environ. Microbiol. 2018, 20, 324–336. [Google Scholar] [CrossRef] [PubMed]
- Paul, C.; Filippidou, S.; Jamil, I.; Kooli, W.; House, G.L.; Estoppey, A.; Hayoz, M.; Junier, T.; Palmieri, F.; Wunderlin, T. Bacterial spores, from ecology to biotechnology. Adv. Appl. Microbiol. 2019, 106, 79–111. [Google Scholar] [PubMed]
- Aono, R.; Horikoshi, K. Carotenes produced by alkaliphilic yellow-pigmented strains of Bacillus. Agric. Biol. Chem. 1991, 55, 2643–2645. [Google Scholar] [CrossRef]
- Sohail, M.; Latif, Z. Phylogenetic analysis of polygalacturonase-producing Bacillus and Pseudomonas isolated from plant waste material. Jundishapur J. Microbiol. 2016, 9, e28594. [Google Scholar] [CrossRef]
- Hoondal, G.S.; Tiwari, R.P.; Tewari, R.; Dahiya, N.; Beg, Q.K. Microbial alkaline pectinases and their industrial applications: A review. Appl. Microbiol. Biotechnol. 2002, 59, 409–418. [Google Scholar] [CrossRef]
- Di Candilo, M.; Bonatti, P.M.; Guidetti, C.; Focher, B.; Grippo, C.; Tamburini, E.; Mastromei, G. Effects of selected pectinolytic bacterial strains on water-retting of hemp and fibre properties. J. Appl. Microbiol. 2010, 108, 194–203. [Google Scholar] [CrossRef]
- Cheng, L.; Wang, Q.; Feng, X.; Duan, S.; Yang, Q.; Zheng, K.; Liu, Z.; Liu, Z.; Peng, Y. Screening a bacterium and its effect on the biological degumming of ramie and kenaf. Sci. Agric. 2018, 75, 375–380. [Google Scholar] [CrossRef]
- Nath, M.; Majumdar, B.; Das, S.; Mazumdar, S.P.; Saha, A.; Sarkar, S. Optimization of Fermentation Conditions for pectin degrading enzyme production by pectinolytic microbial consortia used for jute retting. Int. J. Curr. Microbiol. Appl. Sci. 2017, 6, 925–931. [Google Scholar] [CrossRef]
- Das, S.; Majumdar, B.; Saha, A.; Sarkar, S.; Jha, S.; Sarkar, S.; Saha, R. Comparative study of conventional and improved retting of jute with microbial formulation. Proc. Natl. Acad. Sci. India Sect. B Biol. Sci. 2018, 88, 1351–1357. [Google Scholar] [CrossRef]
- Bajpai, P. Bioconversion of hemicelluloses. In Biotechnology for Pulp and Paper Processing; Springer: Berlin/Heidelberg, Germany, 2018; pp. 545–560. [Google Scholar]
- Song, Y.; Jiang, W.; Zhang, Y.; Ben, H.; Han, G.; Ragauskas, A.J. Isolation and characterization of cellulosic fibers from kenaf bast using steam explosion and Fenton oxidation treatment. Cellulose 2018, 25, 4979–4992. [Google Scholar] [CrossRef]
- Krulwich, T.A.; Guffanti, A.A.; Ito, M. pH tolerance in Bacillus: Alkaliphiles versus non-alkaliphiles. Bact. Responses pH 1999, 221, 167. [Google Scholar]
- Hu, X.; Mahillon, J. Life Cycle and Gene Exchange. In Endospore-Forming Soil Bacteria; Springer: Berlin/Heidelberg, Germany, 2011; pp. 89–113. [Google Scholar]
- Radhakrishnan, R.; Hashem, A.; Abd-Allah, E.F. Bacillus: A biological tool for crop improvement through bio-molecular changes in adverse environments. Front. Physiol. 2017, 8, 667. [Google Scholar] [CrossRef] [PubMed]
- Henriksson, G.; Akin, D.E.; Hanlin, R.T.; Rodriguez, C.; Archibald, D.D.; Rigsby, L.L.; Eriksson, K.L. Identification and retting efficiencies of fungi isolated from dew-retted flax in the United States and europe. Appl. Environ. Microbiol. 1997, 63, 3950–3956. [Google Scholar] [CrossRef] [PubMed]
- Song, Y.; Jiang, W.; Nie, K.; Zhang, Y.; Ben, H.; Han, G.; Ragauskas, A.J. An alkali-free method to manufacture ramie fiber. Text. Res. J. 2019, 89, 3653–3659. [Google Scholar] [CrossRef]
- Rozyanty, A.; Zhafer, S.; Shayfull, Z.; Nainggolan, I.; Musa, L.; Zheing, L. Effect of water and mechanical retting process on mechanical and physical properties of kenaf bast fiber reinforced unsaturated polyester composites. Compos. Struct. 2021, 257, 113384. [Google Scholar] [CrossRef]
- Nie, K.; Liu, B.; Zhao, T.; Wang, H.; Song, Y.; Ben, H.; Ragauskas, A.J.; Han, G.; Jiang, W. A facile degumming method of kenaf fibers using deep eutectic solution. J. Nat. Fibers 2020, 19, 1115–1125. [Google Scholar] [CrossRef]
- Jiang, W.; Han, G.; Zhang, Y.; Liu, S.; Zhou, C.; Song, Y.; Zhang, X.; Xia, Y. Monitoring chemical changes on the surface of kenaf fiber during degumming process using infrared microspectroscopy. Sci. Rep. 2017, 7, 1240. [Google Scholar] [CrossRef]
- Beltran, R.; Hurren, C.J.; Kaynak, A.; Wang, X. Correlating the fineness and residual gum content of degummed hemp fibres. Fibers Polym. 2002, 3, 129–133. [Google Scholar] [CrossRef][Green Version]
- Misnon, M.I.; Islam, M.M.; Epaarachchi, J.A.; Lau, K.-T. Potentiality of utilising natural textile materials for engineering composites applications. Mater. Des. 2014, 59, 359–368. [Google Scholar] [CrossRef]
- Meshram, J.H.; Palit, P. Biology of industrial bast fibers with reference to quality. J. Nat. Fibers 2013, 10, 176–196. [Google Scholar] [CrossRef]
- Galiwango, E.; Rahman, N.S.A.; Al-Marzouqi, A.H.; Abu-Omar, M.M.; Khaleel, A.A. Isolation and characterization of cellulose and α-cellulose from date palm biomass waste. Heliyon 2019, 5, e02937. [Google Scholar] [CrossRef] [PubMed]
- Guo, Y.; Wu, P. Investigation of the hydrogen-bond structure of cellulose diacetate by two-dimensional infrared correlation spectroscopy. Carbohydr. Polym. 2008, 74, 509–513. [Google Scholar] [CrossRef]
- Le Troedec, M.; Sedan, D.; Peyratout, C.; Bonnet, J.P.; Smith, A.; Guinebretiere, R.; Gloaguen, V.; Krausz, P. Influence of various chemical treatments on the composition and structure of hemp fibres. Compos. Part A Appl. Sci. Manuf. 2008, 39, 514–522. [Google Scholar] [CrossRef]
- Saelee, K.; Yingkamhaeng, N.; Nimchua, T.; Sukyai, P. An environmentally friendly xylanase-assisted pretreatment for cellulose nanofibrils isolation from sugarcane bagasse by high-pressure homogenization. Ind. Crops Prod. 2016, 82, 149–160. [Google Scholar] [CrossRef]
- Biagiotti, J.; Puglia, D.; Torre, L.; Kenny, J.M.; Arbelaiz, A.; Cantero, G.; Marieta, C.; Llano-Ponte, R.; Mondragon, I. A systematic investigation on the influence of the chemical treatment of natural fibers on the properties of their polymer matrix composites. Polym. Compos. 2004, 25, 470–479. [Google Scholar] [CrossRef]
- Hospodarova, V.; Singovszka, E.; Stevulova, N. Characterization of cellulosic fibers by FTIR spectroscopy for their further implementation to building materials. Am. J. Anal. Chem. 2018, 9, 303–310. [Google Scholar] [CrossRef]
- Sheltami, R.M.; Abdullah, I.; Ahmad, I.; Dufresne, A.; Kargarzadeh, H. Extraction of cellulose nanocrystals from mengkuang leaves (Pandanus tectorius). Carbohydr. Polym. 2012, 88, 772–779. [Google Scholar] [CrossRef]
- Zhang, X.; Han, G.; Jiang, W.; Zhang, Y.; Li, X.; Li, M. Effect of steam pressure on chemical and structural properties of kenaf fibers during steam explosion process. BioResources 2016, 11, 6590–6599. [Google Scholar] [CrossRef]

| Treatments | Combinations | Designations |
|---|---|---|
| T1 | Uninoculated with seawater | USW |
| T2 | Uninoculated with freshwater | UFW |
| T3 | APPB1 with seawater | APPB1 + SW |
| T4 | APPB1 with freshwater | APPB1 + FW |
| T5 | APPB2 with seawater | APPB2 + SW |
| T6 | APPB2 with sresh water | APPB2 + FW |
| Retting Treatments | Test Score |
|---|---|
| USW | 1.50 (2,2,1,1) |
| UFW | 1.0 (1,1,1,1) |
| APPB1 + SW | 4.75 (5,5,4,5) |
| APPB1 + FW | 4.25 (5,4,4,4) |
| APPB2 + SW | 3.75 (4,4,4,3) |
| APPB2 + FW | 3.5 (4,4,3,3) |
| Treatments | Fiber Bundles Mean Diameter (µm) | Fineness Gtex (Equal to g/103 m of Fiber Length) |
|---|---|---|
| UFW | 105.86 | 12.74 |
| USW | 102.13 | 11.87 |
| APPB1 + SW | 84.20 | 7.65 |
| APPB1 + FW | 89.5 | 9.11 |
| APPB2 + SW | 93.83 | 10.02 |
| APPB2 + FW | 97.43 | 10.80 |
Publisher’s Note: MDPI stays neutral with regard to jurisdictional claims in published maps and institutional affiliations. |
© 2022 by the authors. Licensee MDPI, Basel, Switzerland. This article is an open access article distributed under the terms and conditions of the Creative Commons Attribution (CC BY) license (https://creativecommons.org/licenses/by/4.0/).
Share and Cite
Hossain, M.M.; Subbiah, V.K.; Siddiquee, S. Augmented Retting Effect on Kenaf Fibers Using Alkalophilic Pectinase-Producing Bacteria in Combination with Water Solvents. Appl. Sci. 2022, 12, 7136. https://doi.org/10.3390/app12147136
Hossain MM, Subbiah VK, Siddiquee S. Augmented Retting Effect on Kenaf Fibers Using Alkalophilic Pectinase-Producing Bacteria in Combination with Water Solvents. Applied Sciences. 2022; 12(14):7136. https://doi.org/10.3390/app12147136
Chicago/Turabian StyleHossain, Mohammad Munir, Vijay Kumar Subbiah, and Shafiquzzaman Siddiquee. 2022. "Augmented Retting Effect on Kenaf Fibers Using Alkalophilic Pectinase-Producing Bacteria in Combination with Water Solvents" Applied Sciences 12, no. 14: 7136. https://doi.org/10.3390/app12147136
APA StyleHossain, M. M., Subbiah, V. K., & Siddiquee, S. (2022). Augmented Retting Effect on Kenaf Fibers Using Alkalophilic Pectinase-Producing Bacteria in Combination with Water Solvents. Applied Sciences, 12(14), 7136. https://doi.org/10.3390/app12147136

